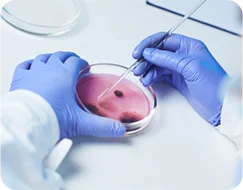

Conheça a infraestrutura de laboratórios e centros de pesquisa e inovação da PUCPR
Centros de pesquisa tecnológicos, laboratórios especializados e profissionais multidisciplinares prontos para criar e transferir inovações para sua empresa
Centros de Pesquisa

Centro Integrado de Soluções em Inteligência Artificial (CISIA)
O CISIA promove a inovação tecnológica, aplicando IA para resolver problemas complexos em diferentes setores, como saúde, educação, agronegócio, indústria, entre outros. O CISIA é credenciado à Agência Nacional do Petróleo, Gás, Natural e Biocombustíveis (ANP), podendo desenvolver P&D ANP.
saiba mais

Centro de Pesquisa e Inovação em Sistemas Elétricos Inteligentes (CISEI)
O CISEI atua em Sistemas Inteligentes do setor elétrico, desenvolvendo projetos em diversas expertises: Smart Grid, Smart City, Mobilidade, Eficiência Energética, Telecomunicações, Sensores, Inteligência Artificial e Automação. O Laboratório de Geotecnia (LGEO), um dos laboratórios do CISEI, é credenciado à ANP, sendo qualificado para desenvolver P&D ANP.
saiba mais

Centro Integrado em Manufatura Inteligente (CIMI)
O CIMI atua com foco em manufatura avançada e tecnologias da Indústria 4.0, buscando integrar tecnologias de automação, digitalização e inteligência artificial nos processos de produção. Fazem parte deste centro: Laboratório de Pesquisa em Usinagem (LAUS), Laboratório de Caracterização e Ensaios de Materiais (LACEM), Laboratório, Automação e Sistemas (LAS), Laboratório de Sistemas Inteligentes (LASIN) e o Laboratório de Otimização de Sistemas de Controle (LOSC), o qual é credenciado à ANP, como instituição apta para desenvolver P&D ANP.
saiba mais

Centro de Realidade Estendida (CRE)
O CRE aplica tecnologias de realidade estendida para criar experiências imersivas e interativas em diversas áreas, como educação, saúde, entretenimento, arquitetura, design e indústria. São desenvolvidos projetos de simulação, oferecendo novas formas de aprendizado, treinamento, visualização e interação. Ele também é um centro credenciado à ANP, apto para desenvolver P&D ANP.
saiba mais
Fazenda Experimental Gralha Azul (FEGA)
Localizada no município de Fazenda Rio Grande, no Paraná, a Fazenda possui 200 hectares distribuídos em diferentes setores, entre eles, plantio de grandes cultivos, transformação genética de plantas, clínica veterinária escola de animais de grande porte e leiteria robotizada. Oferece infraestrutura para o desenvolvimento de projetos de pesquisa e inovação, permitindo que alunos, professores e pesquisadores testem novas técnicas, tecnologias e práticas agrícolas.
saiba mais
Laboratórios

Laboratório de Sistemas Térmicos (LST)
O LST possui experiência no desenvolvimento de software na área de energia e umidade. O espaço é composto por duas câmaras climatizadas com controle de temperatura e umidade para ensaios de eficiência energética e desempenho térmico de refrigeradores, condicionadores de ar, bombas de calor, painéis fotovoltaicos, gabinetes de telecomunicações, máquinas térmicas equipamentos em geral.

Laboratório de Engenharia de Reabilitação (LER)
Desenvolve pesquisas em reabilitação terapêutica e funcional de pessoas com deficiências e de tecnologia assistiva, visando o fornecimento de produtos ou serviços clínicos e tecnológicos voltados ao atendimento das necessidades de pessoas com deficiências sensoriais, neuromotoras e de comunicação, visando sua autonomia, independência, qualidade de vida e inclusão social.

Laboratório de Dinâmica (LABDIN)
Focado em linhas de pesquisa ligadas diretamente com vibrações e acústica, desde a análise numérica até o desenvolvimento de metodologias experimentais. Conta com uma equipe capacitada para atuar em diversos tipos de problemas técnicos ou acadêmico.

Unidade de pesquisa com Xenobióticos
Voltado aos estudos envolvendo Microbiologia, Farmacologia e Bioquímica. Dispõe de infraestrutura para ensaios de crescimento de microrganismos (Biorreator, Fluxo laminar, Sistemas para cultivo de anaeróbios) e dosagens bioquímicas (Espectrofotômetro UV-Vis, Leitora de placas tipo ELISA, HPLC).

Laboratório de Bioquímica
Equipado com tecnologia de ponta e infraestrutura moderna, conta com equipamentos avançados como espectrofotômetros, estufas, centrífugas, banhos-maria, pHmetros, vórtex, geladeiras, freezer e balança de precisão para garantir resultados de alta qualidade em análises, ensaios e projetos.

Laboratório de Biotecnologia
Conheça o laboratório equipado com tecnologia de ponta e equipamentos avançados, como; termociclador, vórtex, minispin, geladeiras, BODs, freezer, centrífugas, balança analítica, autoclaves, câmaras de fluxo laminar e microscópios. Ele oferece o ambiente ideal para pesquisa e desenvolvimento em áreas como saúde, agricultura e ciências biológicas.
Laboratório de Microbiologia
Oferece suporte para projetos que vão desde as investigações básicas aos estudos complexos e abordam temas como resistência bacteriana, biotecnologia e microbiologia ambiental. Equipado com modernos microscópios, autoclaves e incubadoras, o laboratório de microbiologia para garantir resultados precisos e de alta qualidade.

Laboratório Multiuso
Os Laboratórios Multiuso (I, II e III) da PUCPR oferecem um ambiente dinâmico e estruturado para diversas áreas, incluindo microbiologia de animais e plantas, patologias clínicas de interesse veterinário, bioquímica, hematologia, dissecação de animais de interesse parasitológico, ensaios parasitológicos, entomologia, nutrição de plantas e análises químicas do solo.

Laboratório de Tecnologia de Cosméticos e Homeopatia
Além de recursos para elaboração de fórmulas, o laboratório oferece estrutura para estudo de ingredientes ativos e a análise de propriedades físicas e químicas dos produtos. A infraestrutura é equipada com tecnologias avançadas e materiais necessários para garantir a segurança e eficiência nas pesquisas, contribuindo para o desenvolvimento de produtos de qualidade e sustentáveis que atendem às necessidades do público contemporâneo.

Laboratório de Tecnologia Farmacêutica
Espaço inovador, com infraestrutura equipada para pesquisa e desenvolvimento de projetos que visam contribuir para o avanço da tecnologia farmacêutica e a melhoria da saúde pública.